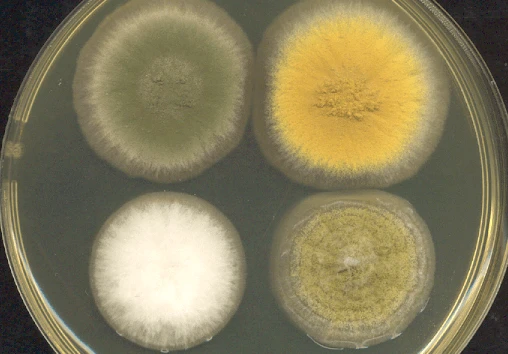

Key to creating tastier cultured meats and animal-free dairy? Fungi
Key to creating tastier cultured meats and animal-free dairy? Fungi


One of the most promising sources of innovative foods is fungi – a diverse kingdom of organisms that naturally produce a huge range of tasty and nutritious proteins, fats, antioxidants, and flavor molecules. Chef-turned-bioengineer Vayu Hill-Maini, an affiliate in the Biosciences Area at Lawrence Berkeley National Laboratory (Berkeley Lab), is exploring the many possibilities for new tastes and textures that can be made from modifying the genes already present in fungi.
“I think it’s a fundamental aspect of synthetic biology that we’re benefiting from organisms that have evolved to be really good at certain things,” said Hill-Maini, who is a postdoctoral researcher at UC Berkeley in the lab of bioengineering expert Jay Keasling. “What we’re trying to do is to look at what is the fungus making and try to kind of unlock and enhance it. And I think that’s an important angle that we don’t need to introduce genes from wildly different species. We’re investigating how we can stitch things together and unlock what’s already there.”
In their recent paper, published [March 14] in Nature Communications, Hill-Maini and colleagues at UC Berkeley, the Joint BioEnergy Institute, and the Novo Nordisk Foundation Center for Biosustainability studied a multicellular fungus called Aspergillus oryzae, also known as koji mold, that has been used in East Asia to ferment starches into sake, soy sauce, and miso for centuries. First, the team used CRISPR-Cas9 to develop a gene editing system that can make consistent and reproducible changes to the koji mold genome. Once they had established a toolkit of edits, they applied their system to make modifications that elevate the mold as a food source. First, Hill-Maini focused on boosting the mold’s production of heme – an iron-based molecule which is found in many lifeforms but is most abundant in animal tissue, giving meat its color and distinctive flavor. (A synthetically produced plant-derived heme is also what gives the Impossible Burger its meat-duping properties.) Next, the team punched up production of ergothioneine, an antioxidant only found in fungi that is associated with cardiovascular health benefits.
After these changes, the once-white fungi grew red. With minimal preparation – removing excess water and grinding – the harvested fungi could be shaped into a patty, then fried into a tempting-looking burger.

Hill-Maini’s next objective is to make the fungi even more appealing by tuning the genes that control the mold’s texture. “We think that there’s a lot of room to explore texture by varying the fiber-like morphology of the cells. So, we might be able to program the structure of the lot fibers to be longer which would give a more meat-like experience. And then we can think about boosting lipid composition for mouth feel and further nutrition,” said Hill-Maini, who was a Fellow of the Miller Institute for Basic Research in Science at UC Berkeley during the study. “I’m really excited about how can we further look at the fungus and, you know, tinker with its structure and metabolism for food.”
Though this work is just the beginning of the journey to tap into fungal genomes to create new foods, it showcases the huge potential of these organisms to serve as easy-to-grow protein sources that avoid the complex ingredients lists of current meat substitutes and the cost barriers and technical difficulties hindering the launch of cultured meat. Additionally, the team’s gene editing toolkit is a big leap forward for the field of synthetic biology as a whole. Currently, a great variety of biomanufactured goods are made by engineered bacteria and yeast, the single-celled cousins of mushrooms and mold. Yet despite humanity’s long history of domesticating fungi to eat directly or to make staples like miso, multicellular fungi have not yet been harnessed as engineered cellular factories to the same extent because their genomes are far more complex, and have adaptations that make gene editing a challenge. The CRISPR-Cas9 toolkit developed in this paper lays the foundation to easily edit koji mold and its many relatives.

“These organisms have been used for centuries to produce food, and they are incredibly efficient at converting carbon into a wide variety of complex molecules, including many that would be almost impossible to produce using a classic host like brewer’s yeast or E. coli,” said senior author Jay Keasling, who is a senior scientist at Berkeley Lab and a professor at UC Berkeley. “By unlocking koji mold through the development of these tools, we are unlocking the potential of a huge new group of hosts that we can use to make foods, valuable chemicals, energy-dense biofuels, and medicines. It’s a thrilling new avenue for biomanufacturing.”
Given his culinary background, Hill-Maini is keen to ensure that the next generation of fungi-based products are not only palatable, but truly desirable to customers, including those with sophisticated tastes. In a separate study, he and Keasling collaborated with chefs at Alchemist, a two-Michelin-starred restaurant in Copenhagen, to play with the culinary potential of another multicellular fungus, Neurospora intermedia. This fungus is traditionally used in Indonesia to produce a staple food called oncom by fermenting the waste products left over from making other foods, such as tofu. Intrigued by its ability to convert leftovers into a protein-rich food, the scientists and chefs studied the fungus in the Alchemist test kitchen. They discovered N. intermedia produces and excretes many enzymes as it grows. When grown on starchy rice, the fungi produces an enzyme that liquifies the rice and makes it intensely sweet. “We developed a process with just three ingredients – rice, water, and fungus – to make a beautiful, striking orange-colored porridge,” said Hill-Maini. “That became a new dish on the tasting menu that utilizes fungal chemistry and color in a dessert. And I think that what it really shows is that there’s opportunity to bridge the laboratory and the kitchen.”
Read the original post here

 | Videos | More... |

Video: Nuclear energy will destroy us? Global warming is an existential threat? Chemicals are massacring bees? Donate to the Green Industrial Complex!
 | Bees & Pollinators | More... |

GLP podcast: Science journalism is a mess. Here’s how to fix it

Mosquito massacre: Can we safely tackle malaria with a CRISPR gene drive?

Are we facing an ‘Insect Apocalypse’ caused by ‘intensive, industrial’ farming and agricultural chemicals? The media say yes; Science says ‘no’
 | Infographics | More... |

Infographic: Global regulatory and health research agencies on whether glyphosate causes cancer
 | GMO FAQs | More... |

Why is there controversy over GMO foods but not GMO drugs?

How are GMOs labeled around the world?

How does genetic engineering differ from conventional breeding?
 | GLP Profiles | More... |

Alex Jones: Right-wing conspiracy theorist stokes fear of GMOs, pesticides to sell ‘health supplements’




 Viewpoint — Fact checking MAHA mythmakers: How wellness influencers and RFK, Jr. undermine American science and health
Viewpoint — Fact checking MAHA mythmakers: How wellness influencers and RFK, Jr. undermine American science and health Viewpoint: Video — Big Solar is gobbling up productive agricultural land and hurting farmers yet providing little energy or sustainabilty gains
Viewpoint: Video — Big Solar is gobbling up productive agricultural land and hurting farmers yet providing little energy or sustainabilty gains Fighting deforestation with CO2: Biotechnology breakthrough creates sustainable palm oil alternative for cosmetics
Fighting deforestation with CO2: Biotechnology breakthrough creates sustainable palm oil alternative for cosmetics Trust issues: What happens when therapists use ChatGPT?
Trust issues: What happens when therapists use ChatGPT? 30-year-old tomato line shows genetic resistance to devastating virus
30-year-old tomato line shows genetic resistance to devastating virus California, Washington, Oregon forge immunization alliance to safeguard vaccine access against federal undermining
California, Washington, Oregon forge immunization alliance to safeguard vaccine access against federal undermining The free-range chicken dilemma: Better for birds, but with substantial costs
The free-range chicken dilemma: Better for birds, but with substantial costs ‘You have to treat the brain first’: Rethinking chronic pain with Sanjay Gupta
‘You have to treat the brain first’: Rethinking chronic pain with Sanjay Gupta
